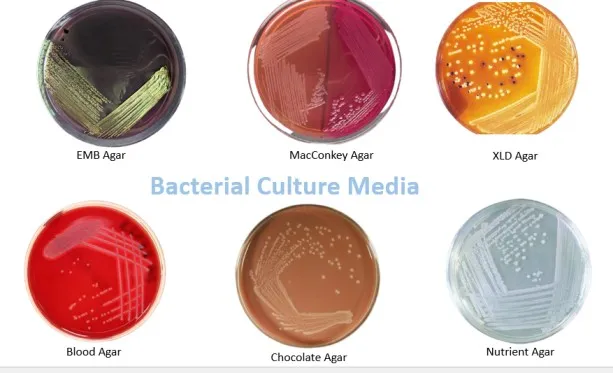
- Common bacterial culture media

Defined media and complex media are two broad classes of culture media used in microbiology. Defined media are prepared by adding precise amounts of highly purified inorganic or organic chemicals to distilled water. Therefore, the exact composition of a defined medium is known.
Complex media are prepared using digests of microbial, animal, or plant products. Casein (milk protein), beef (beef extract), soybeans (tryptic soy broth), yeast cells (yeast extract), or any other highly nutritious yet impure substances are used to prepare complex media; thus, the exact composition of the medium is not known. For culturing many microorganisms, this information is not essential either.
Culture media contains nutrients and physical growth parameters necessary for microbial growth. If a culture medium meets a bacterial cell’s growth requirements, then that cell will multiply to sufficient numbers to allow visualization by the unaided eye. Bacterial culture media can be classified based on composition, consistency, and purpose.
All microorganisms cannot grow in a single culture medium; many can’t grow in any known culture medium. Organisms that cannot grow in the artificial culture medium are obligate parasites. Mycobacterium leprae,Rickettsia, Chlamydia trachomatis, and Treponema pallidum are obligate intracellular parasites.
Based on Consistency
Culture media are divided into three types; solid medium, semi-solid medium, and liquid medium, based on consistency. The percentage of agar used determines the consistency of the medium.
Solid Medium
It contains agar at a concentration of 1.5-2.0% or some other primarily inert solidifying agent. Solid medium has a physical structure and allows bacteria to grow in physically informative or useful ways (e.g., as colonies or in streaks). MacConkey agar, chocolate agar, nutrient agar, blood agar, etc., are some examples of solid culture media.
Uses of solid culture media
- For isolating bacteria from various types of specimen
- For determining the colony characteristics of the isolate (such as colony morphology, hemolysis, pigment production, etc.
- For performing antimicrobial susceptibility testing using the Kirby Bauer disc diffusion method

Semisolid Medium
This type of culture media are prepared with agar at 0.5% or less concentrations. Semisolid medium has a soft custard-like consistency and is helpful for the cultivation ofmicroaerophilic bacteriaor for determining bacterial motility. Motility test medium, Stuart’s and Amies transport media, etc., are semisolid media.
Liquid (Broth) Medium
These media contain specific amounts of nutrients but don’t have a trace of gelling agents such as gelatin or agar. Commonly used liquid media in the lab are; nutrient broth, glucose broth, brain-heart infusion (BHI) broth, alkaline peptone water (APW), tryptic soy broth (TSB), and selenite F broth. Broth medium serves various purposes such as propagation of many organisms, fermentation studies, and various other tests.
Uses of liquid culture media
- To grow bacteria for motility testing
- To grow bacteria for inoculum production for antibiogram testing
- To revive bacteria from lyophilized or stock culture
- To study metabolism, toxin, and enzyme production
- To enrich and/or transport clinical material
Bacteria with complex nutritional requirements are called fastidious bacteria. Special nutritional supplements must be added to culture media to grow such bacteria. Bacteria having relatively basic and straightforward nutritional requirements are easy to grow in a lab, they are known as nonfastidious bacteria.
Based on Functional Use
Many special-purpose media are needed to facilitate the recognition, enumeration, and isolation of certain types of bacteria. To meet these needs, numerous media are available.
Based on their practical use, there are six types of standard culture media in microbiology laboratories. They are; general-purpose (basal) media, enriched media, selective or enrichment media, differential or indicator media, transport media, anaerobic media, and assay media.
General-PurposeMedia

Basal media, also called general-purpose media, are simple media that support the growth of most non-fastidious bacteria. Peptone Water, nutrient broth, and nutrient agar (NA) are basal media. These media are generally used for the primary isolation of microorganisms.
Enriched Media

Adding extra nutrients, such as blood, serum, egg yolk, etc., to the basal medium makes an enriched medium. Enriched media are used to grow nutritionally exacting (fastidious) bacteria. Blood agar, chocolate agar, Loeffler’s serum slope, etc., are a few examples of enriched media. Blood agar is prepared by adding 5-10% (by volume) blood to a blood agar base. Chocolate agaris also known as heated blood agar or lysed blood agar.
Selective and Enrichment Media
These media are designed to inhibit unwanted commensal or contaminating bacteria and help to recover pathogens from a mixture of bacteria. While selective media are agar-based, enrichment media are liquid. Both these media serve the same purpose. Any agar media can be selective by adding specific inhibitory agents that don’t affect the pathogen of interest. Various approaches to making a medium selective include addition of antibiotics, dyes, chemicals, alteration of pH,****or a combination of these.
If you are interested to know about fungal culture media; you can find this post useful:Common Fungal Culture Media: Their Uses
SelectiveMedia
Principle: Differential growth suppressionSelective medium is designed to suppress some microorganisms’ growth while allowing others’ growth. Selective medium is an agar-based (solid) medium so that individual colonies may be isolated.
Examples of selective media include
- Thayer Martin Agar used to recover Neisseria gonorrhoeae contains antibiotics; vancomycin, colistin, and nystatin.
- Mannitol Salt Agarand Salt Milk Agar used to recover S.aureus contains 10% NaCl.
- Potassium tellurite medium used to recover C.diphtheriae contains 0.04% potassium tellurite.
- MacConkey’s Agar used for Enterobacteriaceaemembers, contains bile salt that inhibits most gram-positive bacteria.
- Pseudosel Agar (cetrimide agar) used to recover Pseudomonas aeruginosa contains cetrimide (antiseptic agent).
- Crystal Violet Blood Agar used to recover S. pyogenes contains 0.0002% crystal violet.
- Lowenstein Jensen Medium used to recover M.tuberculosis is made selective by incorporating malachite green.
- Wilson and Blair’s Agar for recovering S. typhi is rendered selective by the addition of dye brilliant green.
- Selective media such as TCBS Agarfor isolating Vibrio cholerae from fecal specimens have elevated pH (8.5-8.6), inhibiting most other bacteria.

Enrichment Media
The enrichment medium increases the relative concentration of specific microorganisms in the culture before plating on a solid selective medium. Unlike selective media, enrichment culture is typically used as a broth medium. Enrichment media are liquid media that also serves to inhibit commensals in the clinical specimen. Selenite F broth, tetrathionate broth,****and alkaline peptone water (APW) recover pathogens from fecal samples.
Differential/Indicator Media
Certain media are designed to recognize different bacteria based on their colony color. Various approaches include incorporating dyes, metabolic substrates, etc., so those bacteria that utilize them appear as differently colored colonies. Such media are called differential media or indicator media. Differential media allow the growth of more than one microorganism of interest but with morphologically distinguishable colonies.Examples of differential media include:

- Mannitol salts agar (mannitol fermentation = yellow)
- Blood agar (various kinds of hemolysis i.e., α, β and γ hemolysis)
- MacConkey agar(lactose fermenters, pink colonies whereas, non-lactose fermenter produces pale or colorless colonies.
- TCBS(Vibrio cholerae produces yellow colonies due to fermentation of sucrose)
Transport Media
Clinical specimens must be transported to the laboratory immediately after collection to prevent overgrowth of contaminating organisms or commensals and maintain the viability of the potential pathogens. This can be achieved by using transport media. Such media prevent drying (desiccation) of a specimen, maintain the pathogen to commensal ratio, and inhibit the overgrowth of unwanted bacteria. Some of these media (Stuart’s & Amie’s) are semi-solid. The addition of charcoal serves to neutralize inhibitory factors.
- Cary Blair transport medium and Venkatraman Ramakrishnan (VR) medium transport feces from suspected cholera patients.
- Sach’s buffered glycerol saline is used to transport feces from patients suspected of suffering from bacillary dysentery.
- Pike’s medium is used to transport streptococci from throat specimens.
Anaerobic Media
Anaerobic bacteria need special media for growth because they need low oxygen content, reduced oxidation-reduction potential, and extra nutrients.

Media for anaerobes may have to be supplemented with nutrients like hemin, and vitamin K. Such media may also have to be reduced by physical or chemical means. Boiling the medium serves to expel any dissolved oxygen. Adding 1% glucose, 0.1% thioglycollate, 0.1% ascorbic acid, 0.05% cysteine, or red hot iron filings can reduce the medium. Before using, the medium must be boiled in a water bath to expel any dissolved oxygen and then sealed with sterile liquid paraffin.
**Robertson Cooked Meat (RCM)**medium commonly used to grow Clostridium spp contains a 2.5 cm column of bullock heart meat and 15 ml of nutrient broth. Thioglycollate broth contains sodium thioglycollate, glucose, cystine, yeast extract, and casein hydrolysate.
Methylene blue or resazurin is an oxidation-reduction potential indicator incorporated into the medium. Under the reduced conditions, methylene blue is colorless.
Assay Media
These media are used to assay vitamins, amino acids, and antibiotics. E.g., antibiotic assay media are used for determining antibiotic potency by the microbiological assay technique.Other types of medium include;
- Media for enumeration of bacteria,
- Media for characterization of bacteria,
- Maintenance media etc.
Uses of Culture Media
References
| Name of the Media | Primary Purpose |
|---|---|
| Bile esculin agar (BEA ) | It is used for the differential isolation and presumptive identification of group D streptococci and enterococci. |
| Bile esculin azide agar with vancomycin | This selective and differential culture media is commonly used to cultivate vancomycin-resistant enterococci from clinical and surveillance specimens. |
| Blood Agar | Blood agar is used for the cultivation of fastidious microorganisms. It is a differential medium that helps to classify/identify the bacteria based on types of hemolysis (alpha, beta or no hemolysis) present. |
| Bordet-Gengou agar | It is used to isolate Bordetella pertussis, the causative agent of pertussis or whooping cough. |
| Buffered Charcoal-yeast extract agar (BCYE) | Enrichment culture media for Legionella spp, the causative agent of Legionnaires’ disease, also known as legionellosis. |
| Buffered Charcoal-yeast extract agar with antibiotics | This culture media is used for the enrichment and selection of Legionella spp |
| Campy-blood agar (Campylobacter Blood Agar) | Selective culture media for Campylobacter spp. Campylobacter is a leading cause of bacterial foodborne diarrheal disease worldwide. |
| Campylobacter thioglycollate broth | Selective holding medium for recovery of Campylobacter spp. |
| Chocolate Agar | Cultivation of Haemophilus spp and pathogenic Neisseria spp. |
| Columbia colistin-nalidixic acid (CNA) agar | Columbia Agar with colistin and nalidixic acid (CNA) is a selective medium for gram-positive organisms. The antimicrobials colistin and nalidixic acid inhibit gram-negative microorganisms. CNA agar is used for the selective isolation of Gram-positive cocci such as staphylococci and streptococci. |
| Cystine-tellurite blood agar | Used for the isolation of Corynebacterium diphtheria. |
| Eosin Methylene Blue (EMB) Agar (Levine) | Isolation and differentiation of lactose fermenting and non-lactose fermenting gram-negative enteric bacilli. |
| Gram-negative broth (GN) | Selective (enrichment) liquid medium for enteric pathogens. |
| Hektoen enteric (HE) agar : | The differential, selective culture medium is used to isolate and differentiate Salmonella and Shigella spp from other gram-negative enteric bacilli. |
| MacConkey Agar | It is commonly used to isolate and differentiate lactose fermenting and non-lactose fermenting gram-negative enteric bacilli. |
| MacConkey Sorbitol Agar | It is a modification of MacConkey agar in which lactose has been replaced with d-sorbitol as the primary carbohydrate. It is used to select and differentiate E.coli O157: H7 from a stool specimen. |
| Mannitol Salt Agar | The primary purpose of MSA is the selective isolation of Staphylococci and differentiation of Staphylococcus aureus from coagulase-negative staphylococci (CONS). |
| New York City Medium | It is a selective culture media for Neisseria gonorrhoeae. |
| Phenylethyl alcohol (PEA) agar | Selective isolation of gram-positive and anaerobic gram-negative bacilli |
| Salmonella-Shigella Agar | Selective for the isolation of Salmonella and Shigella spp. |
| Selenite broth | Used for the enrichment and isolation of Salmonella spp. |
| Tetrathionate broth | Selective for the isolation of Salmonella and Shigella spp. |
| Thayer Martin Agar | Selective culture medium for Neisseria gonorrhoeae and Neisseria meningitidis. |
| Thioglycollate broth | It supports the growth of anaerobes, aerobes, microaerophiles, and fastidious microorganisms. |
| TCBS Agar | It is a selective and differential culture medium for the isolation of Vibrio e.g. Vibrio cholerae , the leading cause of cholera worldwide. |
| Trypticase Soy Broth | It is an enrichment broth for subculturing various bacteria from primary agar plates. |
| Xylose Lysine Desoxycholate (XLD) agar | XLD agar is used to isolate and differentiate Salmonella and Shigella spp from other gram-negative enteric bacilli. |
- Tille, P. M. (2025). Bailey & Scott’s diagnostic microbiology (16th ed.). Elsevier.
- Bonnet, M., Lagier, J. C., Raoult, D., & Khelaifia, S. (2019). Bacterial culture through selective and non-selective conditions: the evolution of culture media in clinical microbiology. New microbes and new infections, 34, 100622. https://doi.org/10.1016/j.nmni.2019.100622